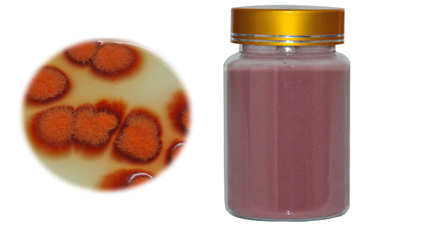

qualityherb's Updates (45)
-
The horny goat weed is originated when the people noticed that the animal like sheep, goats and others who ate the epimedium herbs became excited around opposite sex animals. It helps to boost estrogen levels, especially in post-menopausal women. >>> http://www.qualityherb.net/product/horny-goat-weed-extract.html
-
You can order red yeast rice powder online and get it delivered to your doorstep. We provide special deals and discounts on food supplements and powder. You can save huge money on purchasing the food supplements on our online store. http://www.qualityherb.net/product/red-yeast-rice-powder.html
-
Rhodiola Rosea Extract salidroside powder is one of those unprecedented and strange herbs that have such a critical number of moved advantages, you have to ponder about how Mother Nature could concentrate so much retouching force into a single plant. It can similarly help in the balancing activity of harm and osteoporosis. >>> http://www.qualityherb.net/product/rhodiola-rosea-extract.html
-
Looking for red yeast rice powder online? We are available with so many numbers of food products that you have not seen in such quality. If you choose to buy red yeast rice powder then you can sense the high-quality. http://www.qualityherb.net/product/red-yeast-rice-powder.html
-
Do you know about Horny Goat Weed Extract it is Beneficial for you. Horny goat weed is a herb that has been a conventional cure in China for quite a long time. It's utilized for low moxie, erectile brokenness, exhaustion, torment, and different conditions. http://www.qualityherb.net/product/horny-goat-weed-extract.html
-
http://www.qualityherb.net/product/horny-goat-weed-extract.html Choose the Best Horny Goat Weed Extract at Affordable Rates
-
Horny Goat Weed Extract: Beneficial for Natural Health http://www.qualityherb.net/product/horny-goat-weed-extract.html
-
Qualityherb Prime Day Sale Red Yeast Rice Powder | Beneficial Health Care http://www.qualityherb.net/product/red-yeast-rice-powder.html
-
Natural Colorants Red Yeast Rice Powder | Health & Personal Care | qualityherb.net http://www.qualityherb.net/product/red-yeast-rice-powder.html
-
Red Yeast Rice Powder For Cholesterol | Health & Personal Care http://www.qualityherb.net/product/red-yeast-rice-powder.html
-
Order Best Herbal Extract from Online at Reasonable Cost https://www.techsite.io/p/1103912 [more]
-
Rhodiola Rosea Extract and Red Yeast Rice Beneficial for Lowering Cholesterol http://www.authorstream.com/Presentation/qualityherb-3891961-rhodiola-rosea-extract-red-yeast-rice-beneficial-lowering-chol/ [more]
-
What Are Benefits Of Red Yeast Rice Powder? https://qualityherbextract.blogspot.com/2019/07/what-are-benefits-of-red-yeast-rice.html [more]
-
Rhodiola Rosea Extract and Red Yeast Rice Powder and Grab the Benefits https://qualityherb-51.webself.net/blog/2019/07/08/rhodiola-rosea-extract-and-red-yeast-rice-powder-and-grab-the-benefits1 [more]
-
Take A Look At The Benefits Of Red Yeast Rice Powder http://www.articleted.com/article/130994/6514/Take-A-Look-At-The-Benefits-Of-Red-Yeast-Rice-Powder [more]